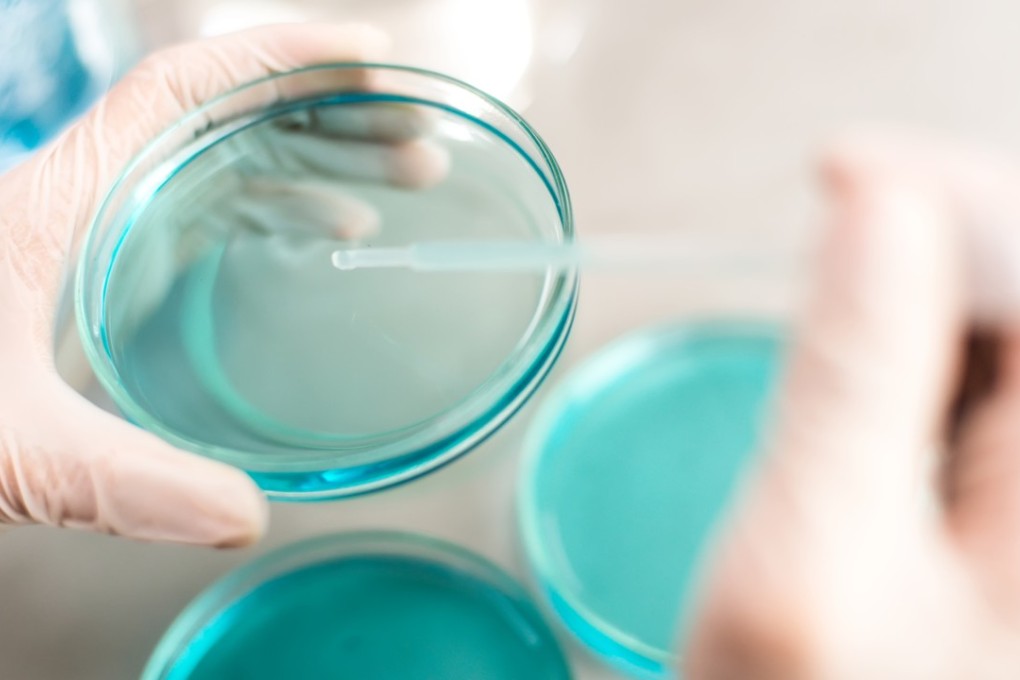
J&J vows to strengthen its manufacturing and innovation investments in China. Photo: Shutterstock

Johnson & Johnson still bullish on Chinese health care industry even as US-China trade war rages on
- The company will open two new manufacturing plants with a combined investment of US$580 million in 2019
US health care giant Johnson & Johnson is aggressively looking to invest further in manufacturing and research in China to strengthen efforts to localise medical innovations for new drugs that address the needs of one of its biggest markets, amid the ongoing trade war between the two countries.
Vladimir Makatsaria, chairman of J&J China, told the South China Morning Post that the company would continue to build “a strong organisation” in China to tap into opportunities in the world’s most populated market.
“We believe in fair and equitable trade, and we think that both people of China and the US will benefit from a good relationship between the countries,” he said. “But our focus is on health care, and that is what we try to worry about.”
A wider manufacturing and research and development base in mainland China will facilitate the scale of clinical tests for innovative drugs that treat diseases like lung cancer, in which 60 per cent of the world’s new incidents are from China.
J&J has nine manufacturing facilities in China. Among the 10,000 employees on the mainland, 700 are scientists engaged in R&D work.
In 2019, the company will open two new manufacturing facilities in the country: one for pharmaceutical products in western Xian city with an investment of about US$400 million, and the other in eastern Suzhou city to produce surgical medical devices, which cost US$180 million.
